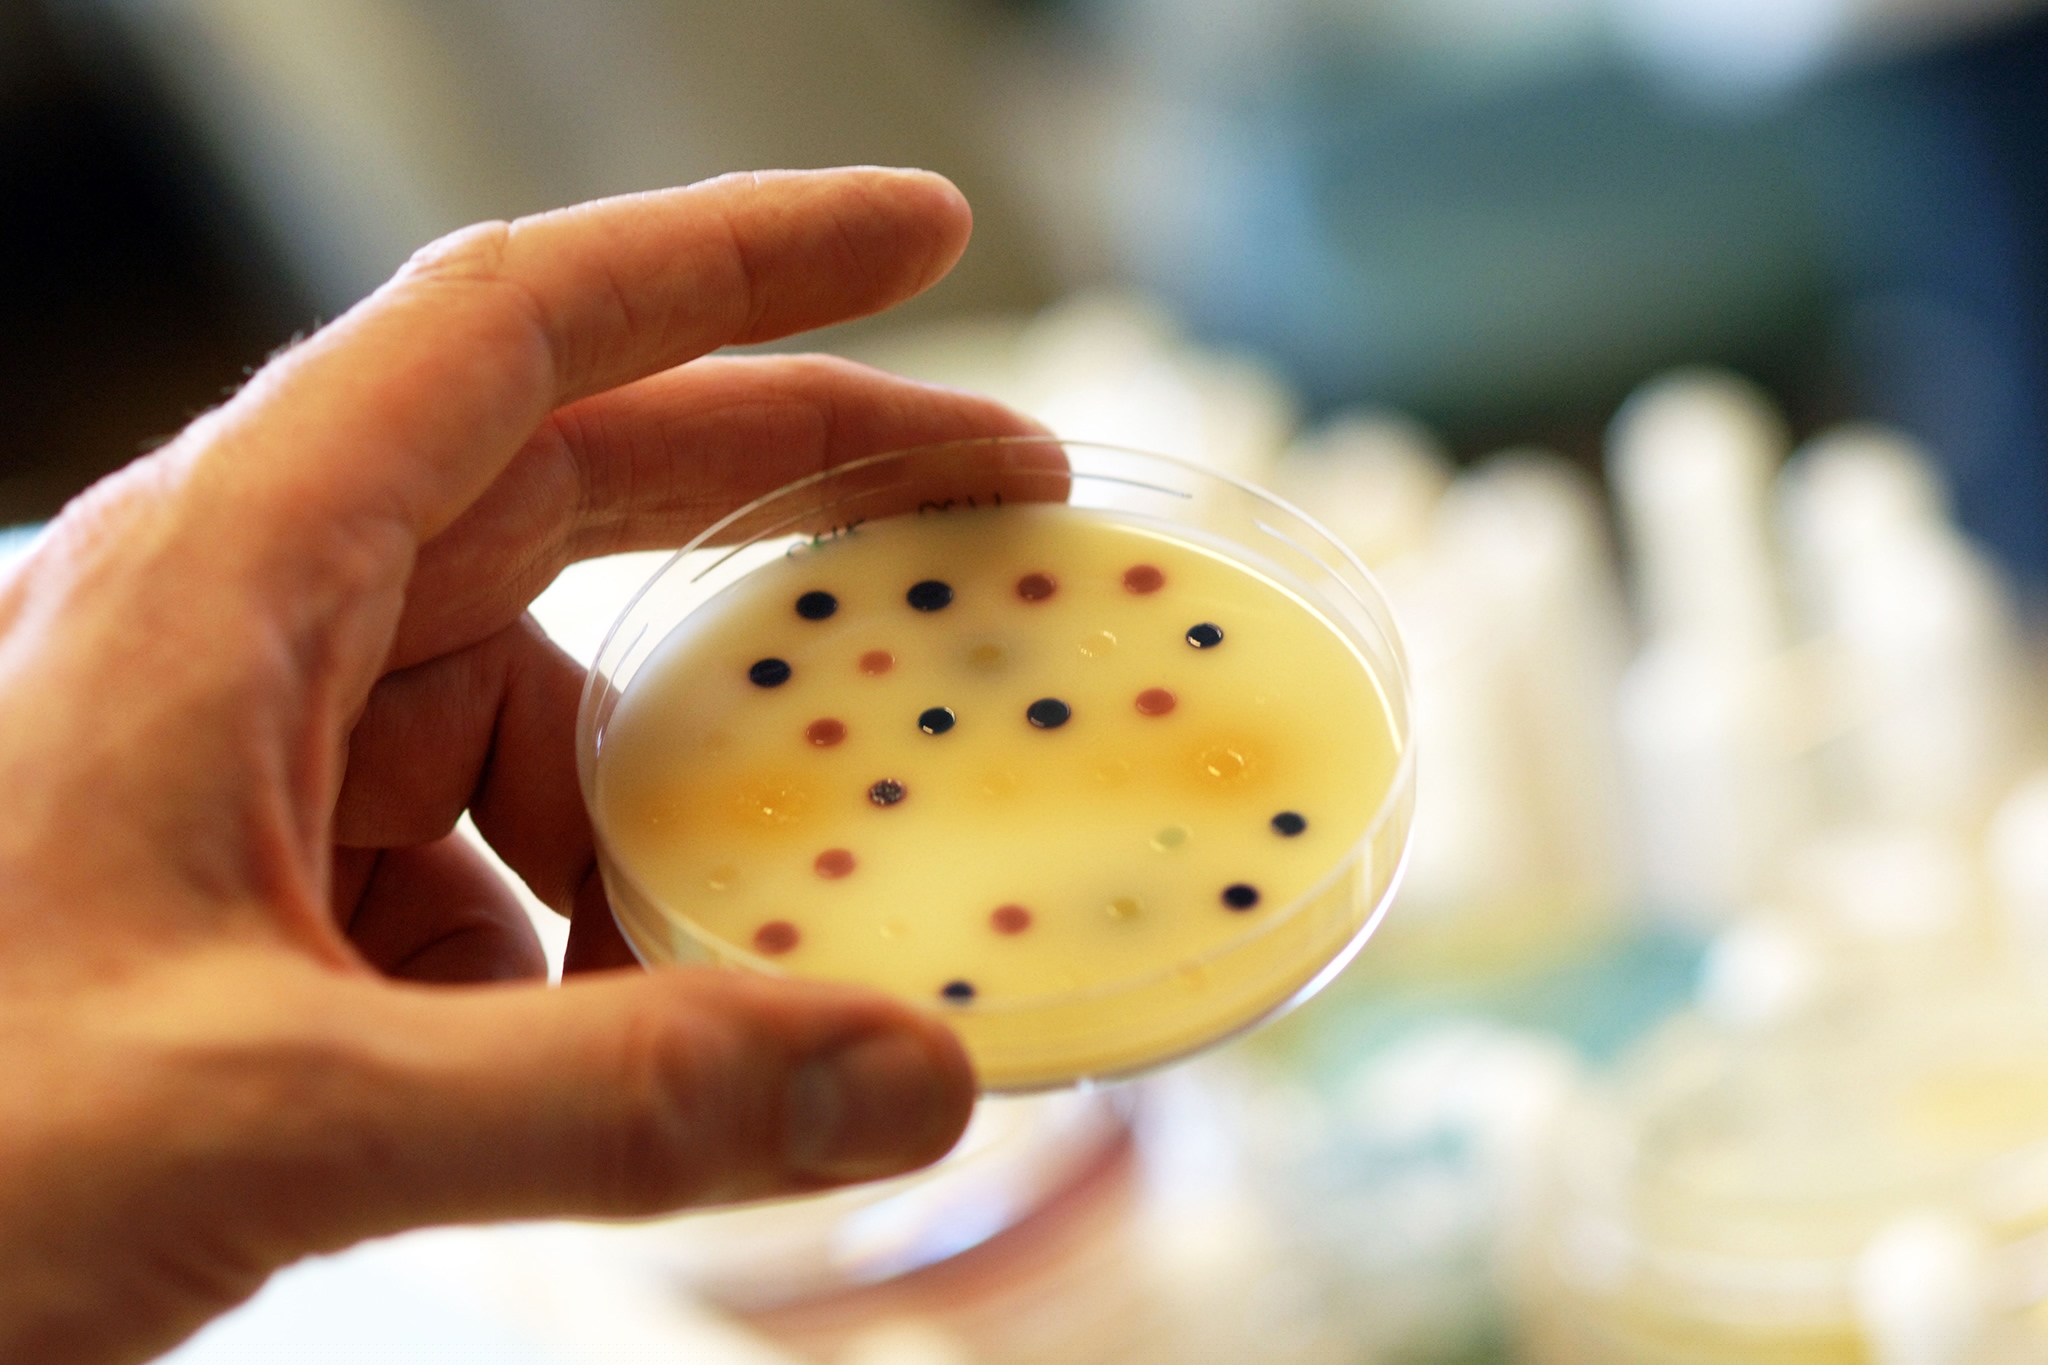

Newest Superbug Has Been in U.S. Longer Than Thought
Resistance to multiple types of last-ditch antibiotics may be spreading through the U.S.—but the lurking bug is hard to find.
It’s been in the U.S. longer than anyone realized, and it’s combining with other types of antibiotic resistance in a manner that signals danger to come.
It’s the “new superbug” MCR—actually a gene, carried by gut bacteria, that confers resistance to the absolutely last-ditch antibiotic colistin.
The newest finding of the gene, being reported by New Jersey scientists in the journal mBio, doesn’t reveal an untreatable superbug—yet. But it raises enough concerns that health authorities are switching tracks, from just looking for the gene in the U.S. to strategizing how to prevent it spreading.
(Why It’s Crucial the New Superbug Was in a Urinary Tract Infection)
The details are these: Microbiologists at Rutgers University have found that, in August 2014, a 76-year-old local man was carrying a strain of E. coli that contained the gene mcr-1, which confers resistance to colistin. The same E. coli strain also possessed a second gene that confers resistance to carbapenems, the second most crucial category of last-resort antibiotics.
Their discovery is significant because it pushes back the timeline of MCR resistance emerging in the U.S. by an additional ten months. Before then, the first instance of the gene in U.S. patients was found in a woman in Pennsylvania in May of this year and the second in a stored sample of E. coli collected in May 2015.
“I don’t think it’s a surprise that we continue to slowly see cases,” Alexander Kallen, a medical officer at the Centers for Disease Control and Prevention, said by phone. “There are actually four cases we know of so far—one is not yet published—and we expect they will increase over time.”
Since its existence was revealed in people, meat, and livestock in China almost a year ago,
global health authorities have been deeply worried about MCR for two reasons. It represented the breach of a last defense, since for some categories of infection colistin is the only antibiotic that still works. And it demonstrated that resistance was on the move: The colistin-resistance gene is contained on a plasmid, a DNA fragment that can reproduce itself and hopscotch rapidly among bacteria. Since its discovery, MCR has been found in more than 30 countries.
Border-Crossing Sleeper Bacteria
The original identification of MCR spurred many researchers—including the authors of today’s paper, who mostly come from the New Jersey Medical School at Rutgers University—to look back in frozen collections of bacteria to see whether it had spread.
“University Hospital, up the street from us in Newark, has been sending us all their carbapenem-resistant isolates for two years,” Jose Mediavilla told me. He’s the first author of the mBio paper and a molecular microbiologist at Rutgers’ Public Health Research Institute Tuberculosis Center. Last January, he ran an analysis on 96 of those samples.
“And we got a match on one isolate, an E. coli strain. And what was really interesting about the match was that the strain was also positive for NDM-5, a subtype of the carbapenem-resistant strain that caused all the headlines a few years ago.” The two resistance factors were on separate plasmids that had both migrated into the E. coli strain.
Mediavilla works in the lab of microbiologist Barry Kreiswirth, whose team have published three of the roughly hundred separate findings of MCR around the world. The lab’s earlier work had all been on samples submitted by colleagues in China; this was the first MCR they found in the U.S. When they checked the identity of the sample, they discovered it had come from a man from India who lives in New Jersey and had a complicated medical history: prostate cancer, radiation treatment, recurrent urinary tract infections, and recent surgery on his urinary tract.
The man had five separate species of resistant bacteria in his urine, including the E. coli that Mediavilla analyzed this year. At the time he was sick, he was treated with an array of antibiotics, and his infection resolved, demonstrating that the MCR+NDM combination has not made his E. coli untreatable. The analysis done this year showed the rogue strain was still susceptible to a small number of antibiotics.
Lance Price, a molecular microbiologist who directs the Antibiotic Resistance Action Center at George Washington University, said this retrospective discovery demonstrates how antibiotic resistance can cross borders invisibly and lurk without being found. “There’s no fever-detection system that you can put in an airport to sense that someone is colonized with a multidrug-resistant E. coli,” he said by phone. “This shows the mobility of these sleeper bacteria, that they can travel the world without being detected.”
It’s important, Price added, to underline that the multidrug-resistant E. coli was found in a urinary tract infection. (It isn’t clear which of the bacteria the man was carrying actually caused his UTI.) “For years we’ve thought of UTIs as being just a painful annoyance, but now they are becoming something that could be deadly, if you cannot successfully treat them with an antibiotic,” he said. “It underscores that resistance could dramatically change our experience of common diseases.”
Big Questions Remain
There’s no evidence that the multidrug-resistant MCR strain spread to others, according to Kallen. When the CDC learned of the New Jersey discovery earlier this summer, they attempted to track down family members and hospital workers and checked to see whether they were carrying the resistant organism. None were, though the amount of time that had elapsed made a thorough investigation difficult.
“We do have a substantial level of concern” about the spread of MCR, he said. “It is disappointing, though not unexpected. But the good news is it seems to have been contained in these individual cases.”
The big remaining questions, which won’t be answered quickly, is how much MCR has spread in the U.S. and when or if it will begin to cause highly resistant infections instead of being a quiescent fellow traveler in the bladder or gut, as seems to have happened so far.
What could cause it to ignite, paradoxically, is more use of the drugs that MCR-carrying bacteria are resistant to. If, for instance, a physician prescribed colistin, that would likely kill most of the bacteria in the near vicinity but leave the resistant, MCR-carrying bacteria to thrive in the suddenly opened living space left by those that were wiped out.
Preventing that from happening requires being very careful about using colistin, as well as the carbapenems in the case of NDM. Most of medicine deploys those drugs conservatively, but as resistance has risen they’re being used more than they used to be.
Plus, there may be stealth use that’s never, until now, been considered important. Intravenous colistin use is confined to hospitals—but the family of drugs that it comes from, the polymyxins, are incredibly common ingredients in over-the-counter antiseptic creams such as Polysporin and Neosporin.
“The thing we are wondering and concerned about is topical use of polymyxin,” Kallen said. “That is a very interesting question: how much the topical preparations influence what goes on in your GI tract” where E. coli reside.
National and hospital programs that emphasize antibiotic stewardship, the process of using drugs conservatively, “haven’t really looked at topical antimicrobials,” he said. “But it is an important unanswered question right now.”